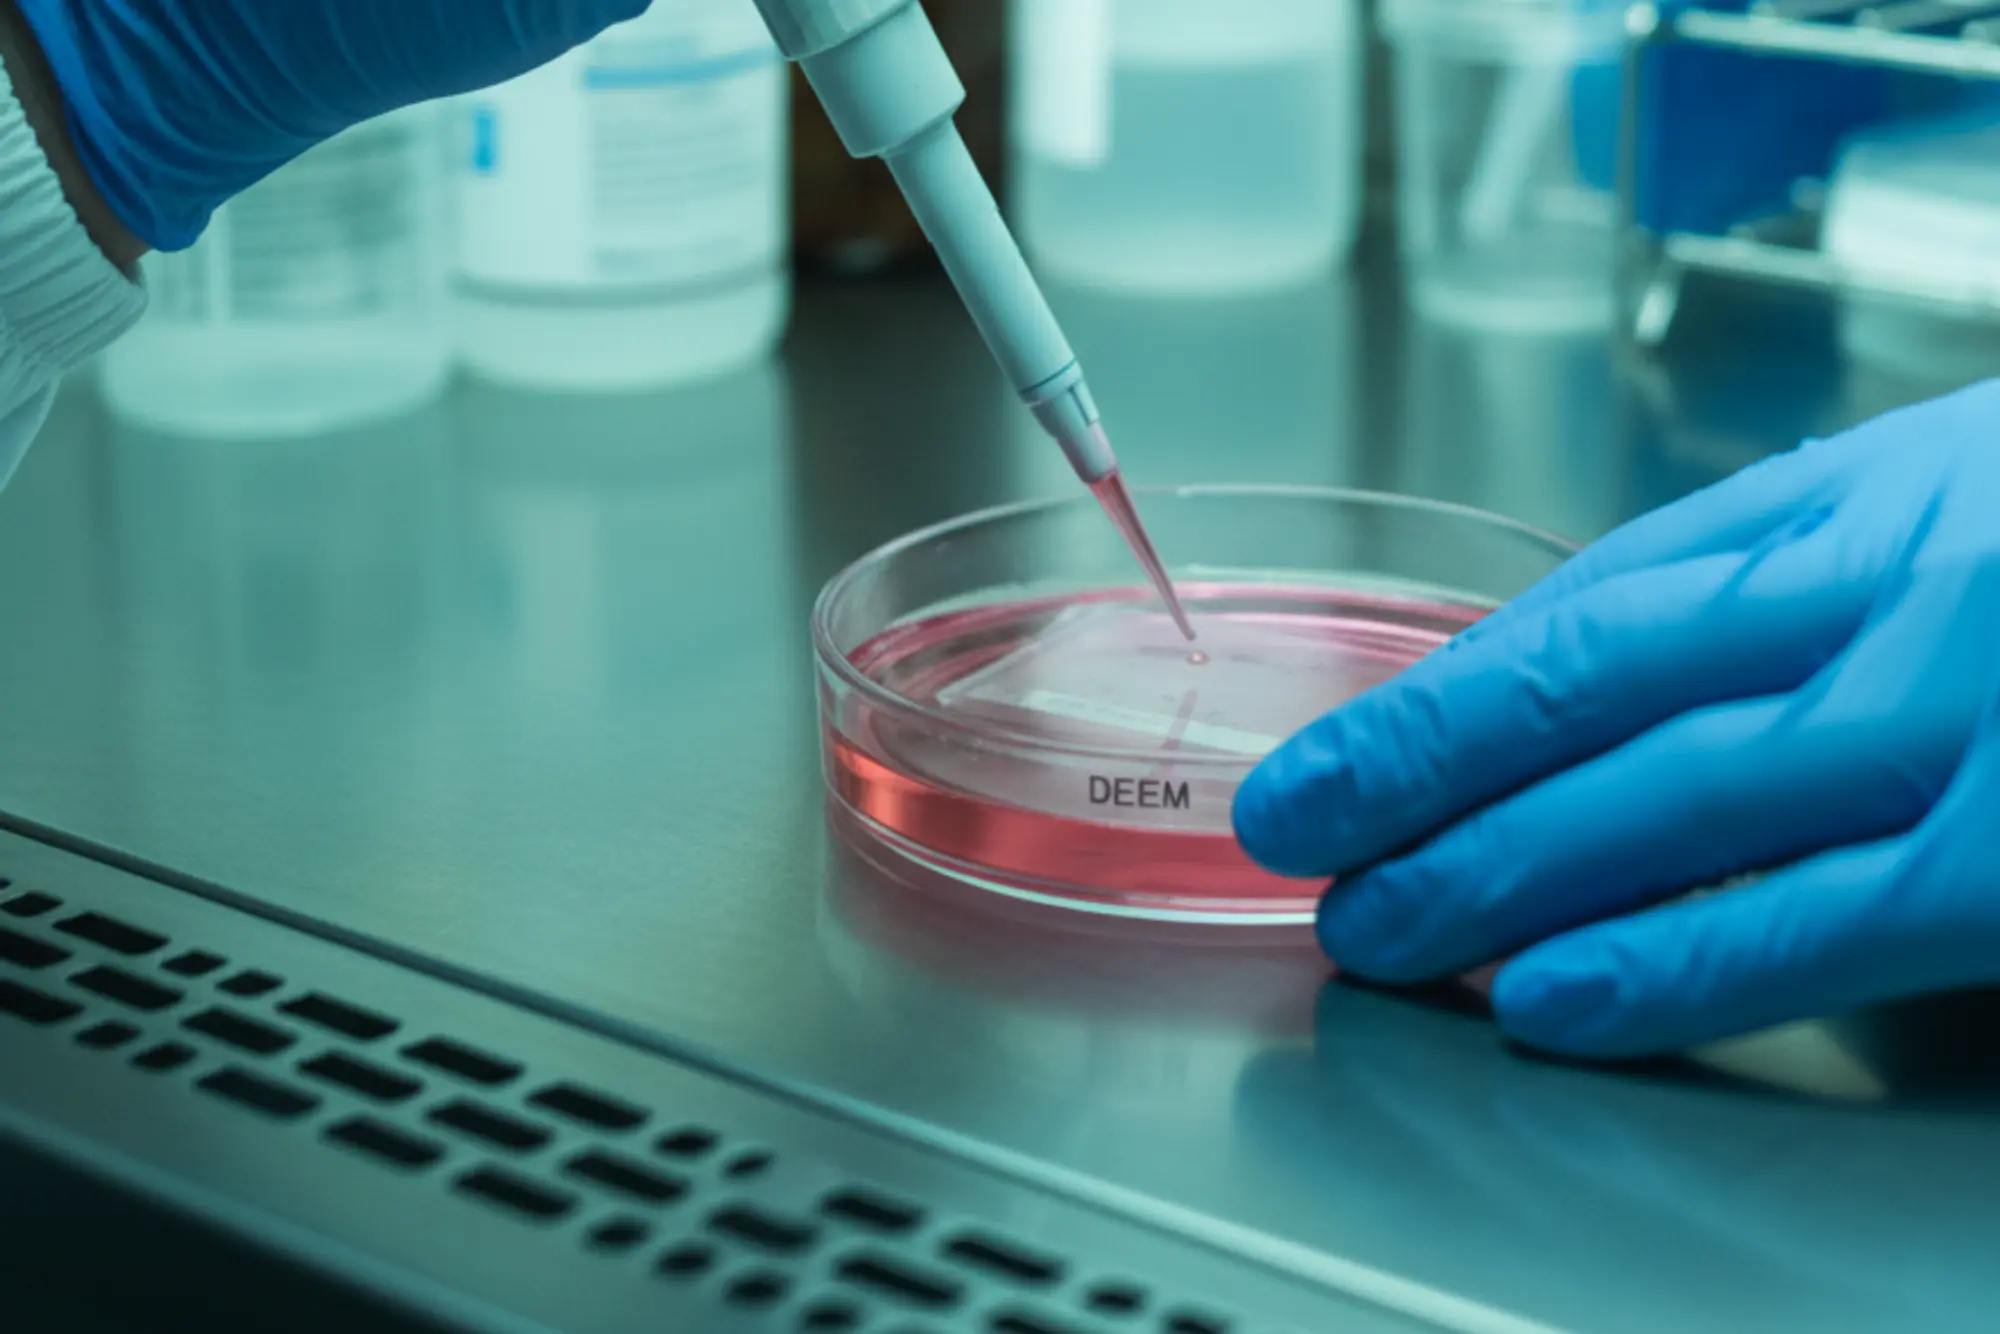

Bioralis Health & Technology
Sağlıkta Bilgi, Gelecekte İnovasyon.
Teknolojinin hızıyla sağlığın güvenini bir araya getiriyoruz. Bioralis Health & Technology olarak, geleceğin çözümlerinin bugünden kullanımıza sunmak için yola çıktık. Amacımız sadece tedavi etmek değil; yaşamın her alanında yanınızda olmak.
Bizimle İletişime GeçinFikirden Ürüne, Sürdürülebilir İnovasyon
Sürekli Eğitim
Sağlık ve teknoloji eğitim programlarımızdan size uygun olanı seçin.
Uygulamalı Öğrenim
Uzman eğitmenler eşliğinde uygulamalı laboratuvar ve teknik eğitimlere katılın.
İnovatif Çözümler
Danışmanlık hizmetimizle yenilikçi çözümleri kurumsal başarıya dönüştürün.
Sonraki Adım
Medikal alanda geliştirdiğimiz ürünlerle her zaman daha iyiye ulaşın